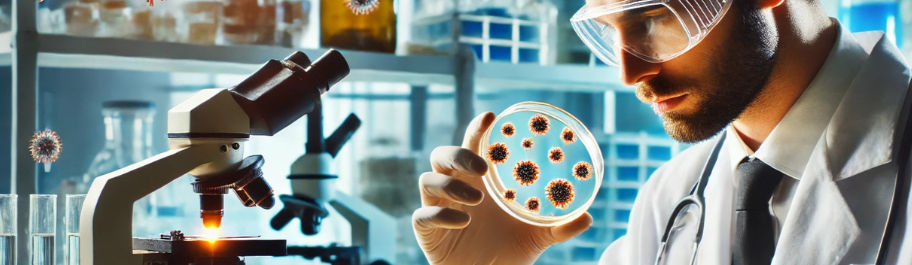
FIID_edited_edited.jpg

Fellowship in Infectious Diseases
Learn infectious disease diagnosis, treatment, control, and emerging virus trends.
1 Year Online Program | Rs. 1,15,000
About Course
In India, about 2 million confirmed malaria cases and 1,000 deaths are reported annually, although WHO estimates 15 million cases and 20,000 deaths, while the disease burden for tuberculosis is 2.5 to 3.5 times higher than the global average. Infectious diseases remain predominant while non-communicable diseases are emerging, imposing a double burden on India's healthcare system. India harbors the highest number of TB cases globally, yet there's a critical shortage of trained infectious disease specialists to manage complex cases and emerging pathogens.
Medigrad's 12 months Fellowship in Infectious Diseases is a comprehensive program designed for MBBS doctors seeking specialized expertise in infectious disease management. This fellowship course equips physicians with advanced knowledge in diagnosis, treatment, and prevention of infectious diseases, preparing them to handle complex cases including tuberculosis, malaria, viral infections, and emerging infectious threats in both community and hospital settings.
Enquire Now
Key Highlights
-
12-month specialized program with comprehensive coverage of bacterial, viral, parasitic, and fungal infections management
-
Advanced training in emerging infectious diseases, antimicrobial resistance, and infection control protocols
-
Expert faculty with infectious disease specialization and experience in tropical medicine and epidemiology
-
Clinical exposure through case-based learning and real-world infectious disease scenarios in hospital settings
-
CPD UK accredited curriculum with flexible online learning and continuous assessment for working doctors
Content
MODULE-1 : INTRODUCTION & APPROACH TO ID| BACTERIAL INFECTIONS GRAM POSITIVE BACTERIA & MYCOBACTERIA
-
Infectiology
-
Epidemiology
-
Historical Aspects of Infection
-
Infectious Diseases Paradigms
-
Evolution of Infectious Diseases
-
Control of Infectious Diseases
-
Diagnosis of Infectious Diseases Part: 1/5
-
Diagnosis of Infectious Diseases Part: 2/5
-
Diagnosis of Infectious Diseases Part: 3/5
-
Diagnosis of Infectious Diseases Part: 4/5
-
Diagnosis of Infectious Diseases Part: 5/5
-
Staphylococcal Diseases
-
Streptococcal Diseases
-
Diphtheria
-
Anthrax & Bacillus Cerus Tetanus
-
Botulism
-
Gas Gangrene
-
Antibiotic Associated Diarrhea Listeriosis
-
Gram Positive Filamentous Bacteria
-
Tuberculosis
-
Leprosy & Other Mycobacteria
MODULE-2 : BACTERIAL INFECTIONS, GRAM NEGATIVE BACTERIA & IMMUNOLOGY OF ID
-
Neisseria Meningitides Infections
-
Neisserial Meningitides Infections
-
Neisseria Gonorroeae Infections
-
Homophilus Infections
-
Whooping Cough
-
Brucellosis
-
Legionella, Moraxella, Francisella
-
Acinettobacter, Gardnerella, Mobiluncus
-
Rickettsial & Orientia- Typhus
-
Rickettsia- Spotted Fever
-
Bartonella, Ehrlichia, Anaplasma, Coxiella
-
Escherichia Coli Infections
-
Klebsiella Infections
-
Shigella, Citrobacter, Enterobacter
-
Typhoid & Salmonellosis
-
Plague & Yersiniosis
-
Cholera and Vibrio
-
Helicobacter, Campylobacter, Pseudomonas
-
Burkholderia, Serratia, Proteus & Pantoea
-
Miscellaneous Gram Negative Bacteria
-
Immunity & Immunity System
-
Antigen & Antibody
MODULE-3 : VIRAL INFECTIONS
-
Introduction & Cassificaitons to Viruses
-
Herpes Simplex Viruses
-
Varicella Zoster Viruses
-
Epstein Barr Viruses
-
Cytomegalovirus – CMV (dsDNA)
-
PoxVirus
-
Bacteriophages (dsDNA)
-
Human Parvoviruses (ssDNA)
-
Reoviruses (dsRNA)
-
Dengue Flavivirus (+ssRNA)
-
CHIKUNGUNYA TOGAVIRUS AND RELATED ALPHA- TOGAVIRUSES (+Ssrna)
-
Japanese Encephalitis B, West Nile And Other Encephalitis causing Flaviviruses (+ssRNA)
-
Yellow Fever, Zika, KFD And Hemorrhagic Fever Flaviviruses
-
Rubella Togavirus (+ssRNA) Astrovirus,Calclivirus and related viruses (+ssRNA)
-
COVID-19 Viruses
MODULE-4 : PROTOZOAL INFECTIONS , MEDICAL ENTOMOLOGY & HELMINTHIC INFECTIONS
-
Introduction to Parasites
-
Medical Entomology & Vector Borne Diseases
-
Protozoa- Amoeba
-
Protozoa- Giardia, Trichomonas. Toxoplasma, Coceidian Parasites
-
Prorozoa- Leishmania, Trypanosoma
-
Protozoa- Malaria & Babesia
-
Helminths – Cestodes – Tapeworms
-
Helminths – Trematodes – Flukes
-
Helminths – Nematodes – Ascaris, Hookworms, Strongyloides
-
Helminths – Nematodes – Enterobius, Trichuris, Trichinella
-
Helminths – Nematodes – Dracunculiasis, Anisakiasis, Larva Migrans
-
Helminths – Nematodes – Rare Nematodes
-
Helminths – Nematodes – Filarial Worms
-
Helminths – Acanthocephala
Frequently Asked Questions (FAQs)
What is the Course & Study Pattern?
What is the Eligibility requirement to enroll for the course?
It is a blended 1 Year course divided into 4 online modules for three months' each. During online modules, you will get the reading material in form of Books, online E-Books, Case Studies, and Video lectures by the panel of senior doctors.
Minimum eligibility for the course is MBBS with Medical Council of India(MCI) or State Council Registration Certificate.
Is this course recognized MCI?
No, the course is not recognized by MCI.
What is the Examination Pattern?
There would be the 1st-semester exam after 6 Months' of course Completion out of first two modules and 2nd-semester exam during 12th Month out of 3rd Module and 4th Module. The semester exams would be in form of MCQs conducted Online which one can give from anywhere. Two attempts would be given for each semester exam and the higher score would be considered.
The final exam will be conducted through Online MCQs and through VIVA conducted through skype.
What is the minimum passing percentage?
The minimum passing percentage is 50% in the final exam. To become eligible for final exam one has to achieve an average of 50% marks in both the semesters. For Example, if you have achieved 40% in 1st semester and 60% in the second semester, it would be taken as 50% and one can appear for the final exam.
How do I enroll myself?
-
Click on Enroll Now button above and you will be directed to Application Form page.
-
Fill in all the required details and upload your education documents.
-
Make the fee payment by clicking the Pay Now button on the Application Form page.
-
You can make the online fee payment through debit/credit card and net banking options.
-
Once you submit the form, education documents, and course fee, you will receive a confirmation e-mail from our side.
Please Note: We only accept online filled application forms and online payment. There is no other mode of enrolling into our courses.
What happens next once I enroll in the course?
As soon you enroll yourself, you will get an email from our side on your registered email id stating the confirmation of your admission. After that, with in the stipulated time period you will receive a welcome email containing your login credentials of the course, program guidance book and course curriculum with important dates. Also, you will get the study material kit at your postal address. You can proceed with studies as per the course commencement dates.
What if I would want to withdraw from the course and get refunded?
The refund option is there. Please refer our Refund Policy page for the details related to it.
Online Simulation Training Partners
SIMTICS is an innovative New Zealand based firm that has been developing and providing online training simulations since 2008. Their interactive simulations are used by learners in over 90 countries to master and perfect their clinical and medical imaging skills.
The SIMTICS learning methodology consists of 3D anatomy, simulations, videos, text and quizzes. A logbook tracks progress and scores.

SIMTICS, New Zealand
Our Alumni are Working & got Trained at

